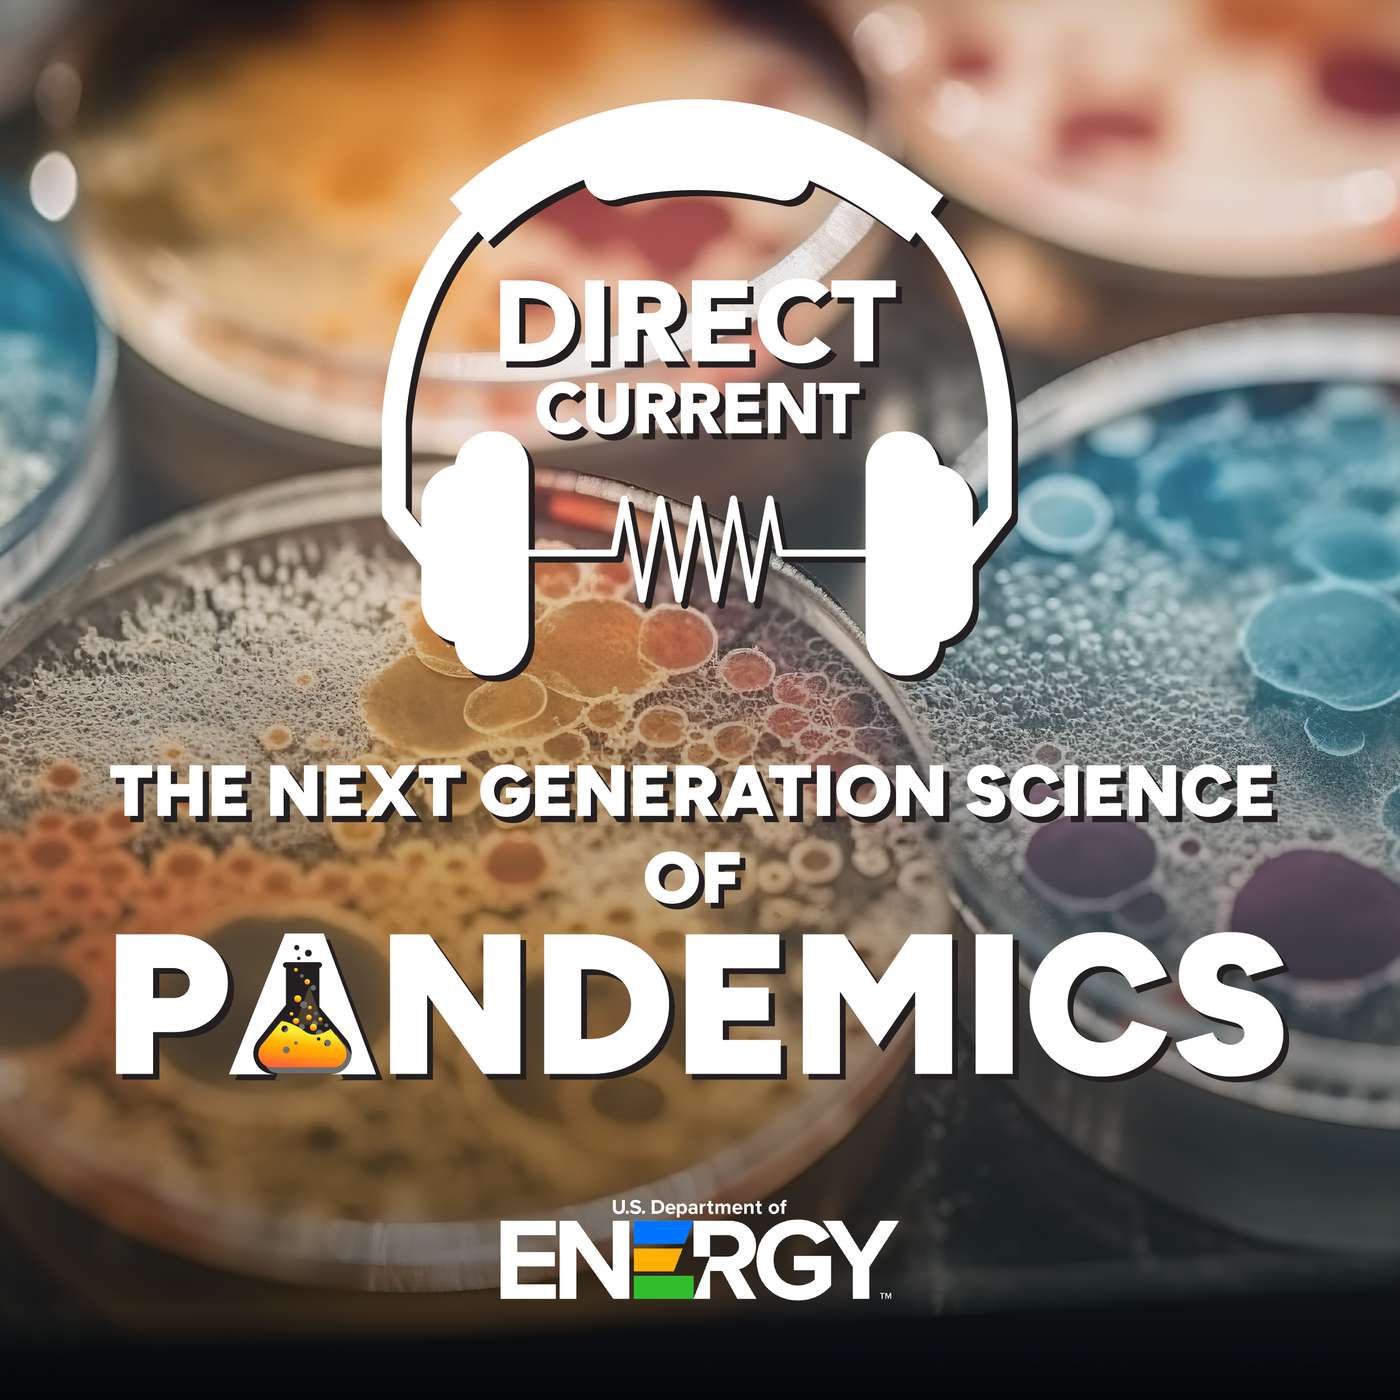
S5 E3: The Next Generation Science of Pandemics

Discover
Direct Current - An Energy.gov Podcast
Direct Current - An Energy.gov Podcast
Author: U.S. Department of Energy
Subscribed: 1,388Played: 21,536Subscribe
Share
© 2025 U.S. Department of Energy
Description
Direct Current is a podcast about energy -- the kind that lights our homes, powers our lives and shapes our world. From the U.S. Department of Energy's digital team in Washington, D.C., Direct Current brings you fresh, insightful stories of how we generate and use electricity, what that means for the planet, and the cutting-edge science that's driving a global energy revolution.
62 Episodes
Reverse
What is exascale computing? Why does it matter? To find out, we connected with the computing experts at DOE's national laboratories. Join us as we discuss the arduous journey to build three of the fastest computers in the world and their software. After more than a decade of planning and work, these powerful exascale computers are now enabling groundbreaking research that wouldn’t be possible otherwise. With research in cancer, biofuels, space exploration, and more, exascale computing is bringing scientific discovery to new heights.
The COVID-19 pandemic serves as a stark reminder that, despite our great achievements, we are still bound by the laws of our own biology. And while the Coronavirus has been a tragedy on a global scale, it has also pushed the scientific community to new levels of cooperation, coordination, and discovery. Join us while we discuss the extraordinary advancements brought about by the National Virtual Biotechnology Laboratory's work during the COVID-19 pandemic. Though we still face many obstacles in pandemic prevention, detection, and mitigation. Thankfully, the DOE and its National laboratories are uniquely qualified to meet these challenges, head-on. We have mobilized like never before, and have powerful new collaborative tools in our arsenal.
The second of two episodes, we’re going under the hood to take a look at something these EVs all share in common — a battery. Where do they come from? How do they work? And how the U.S. is working to meet the demand for millions of batteries for EVs, grid storage, and more.
The first of two episodes, we’re going under the hood to take a look at something these EVs all share in common — a battery. Where do they come from? How do they work? And how the U.S. is working to meet the demand for millions of batteries for EVs, grid storage, and more.
Join us for an energizing conversation with Secretary Jennifer Granholm, focused on the Department of Energy’s 2023 accomplishments and the progress of President Biden’s Investing in America agenda. From shaping the future of transportation to creating thousands of good-paying clean energy jobs. With historic investments in our electric grid to deliver reliable, affordable, clean power to all Americans, including in rural and underserved communities. DOE is focused on a just clean energy economy, ensuring that this historic transition lifts up the most vulnerable among us. Find out how the Investing in America agenda is helping everyday Americans and more on this episode of Direct Current.
70 years ago, President Dwight D. Eisenhower went before the United Nations and delivered a speech unlike anything the world had ever heard. The president spoke in sweeping terms about the terrible destructive power of new atomic weapons. But he also had a message for the assembly, one with a more optimistic tone: Join us in harnessing the power of the atom for good — not evil. From the dawn of the atomic age, nuclear power branched into two distinct paths: nuclear energy, and nuclear weapons. A chain reaction of historical events would lead down one path to the creation and eventual detonation of the world’s first atomic weapons in 1945. Down the other path, work forged ahead on peaceful uses of nuclear power. Join us on a trip through nuclear history, from "Atoms for Peace" to today.
The first of two episodes, we’re going under the hood to take a look at something these EVs all share in common — a battery. Where do they come from? How do they work? And how the U.S. is working to meet the demand for millions of batteries for EVs, grid storage, and more.
The conclusion of our two part story on the Manhattan Project. We take you to the Trinity site where the first bomb was tested and then follow the Airmen as they drop the first ever atomic bombs. Later, learn about the creation of the Department of Energy and how, along with the National Park Service, we're preserving the origins of nuclear power and weaponry.
The first of two episodes that tell the story of an unprecedented, U.S. government effort to beat Nazi Germany in the race to construct a nuclear weapon, the dawn of the atomic age, and how that legacy is being preserved.
In this second episode of season 4 of Direct Current, we dive into a topic that’s been in the news a lot lately: extreme weather. While intense storms have splashed across headlines throughout history, the frequency seems to be increasing. Interviews with Colin Zarzycki, an Assistant Professor at Penn State University, and Alan Rhoades, a research scientist with Lawrence Berkeley National Laboratory, help us explain how climate modeling is helping scientists predict what may lie ahead.
Season 4 of Direct Current opens with a race against the clock, as the Department of Energy and National Labs join forces with industry and international partners to get emergency shipments of electrical grid components to Ukraine — before Russian attacks plunge the country into darkness.
"Quantum" is everywhere these days — in the news, on TV, in the titles of blockbuster action films — but what even is it? Why is it important to understand it? Basically... who cares about quantum?To find out, we got philosophical with National Lab quantum scientists Anna Grassellino and David Awschalom about their brain-bending research, the massive impacts it could have on our lives, and the joy and frustration of chasing breakthroughs that can take decades to arrive. Also: Season 4 of Direct Current is coming soon! Subscribe today wherever you get your podcasts to get a fresh delivery of energy audio goodness in your feed when it drops in spring 2023. Don't miss it!
For years, Chris Castro worked tirelessly to bring a brighter future to the city of Orlando, Florida. We heard from the (now-former) director of sustainability about how he got his start, his passion for clean energy, and the city's resilience efforts.
Conrad Flowers wanted a more fulfilling career, so he followed his passion and took a job in solar energy. Now he’s connecting solar farms to the electric grid and helping train the next generation of engineers.
AlexAnna Salmon is a fierce advocate for her home, a remote Alaskan town called Igiugig. As village council president, she's working to preserve her tribe's traditional way of life amid a warming climate and a shift from fossil fuels to clean energy.
Our series highlighting workers in clean energy continues! Gaby Ibarra, a first-generation college student and daughter of immigrants, shares her journey into a new career helping modernize heating and cooling systems for old buildings in New York City.
In the latest episode of "People Powered," our new series on clean energy careers, wind technician Michael Flores shares what it's like to travel the country and scale 300-foot wind turbines for a living — and why he's sticking with wind for the long run.
Presenting "People Powered," a new series on clean energy careers! There are millions of good-paying jobs in energy, and we'll be introducing you to the folks who do them — starting with Kaly Moore, construction manager at a Washington, DC, solar company.
Contained within a single glass of beer is hundreds of hours of labor and vast amounts of resources. Join us as we go inside a popular craft brewery and learn how DOE programs are helping reduce costs while saving water and energy.
Stretching nearly two miles under a freeway in Palo Alto, CA, the Linac Coherent Light Source (LCLS) is a huge X-ray laser with the power to capture images of molecules in motion. Now, a big upgrade is taking this SLAC Lab facility to the next level.

🔴✅📺📱💻ALL>Movies>WATCH>ᗪOᗯᑎᒪOᗩᗪ>LINK>👉https://co.fastmovies.org